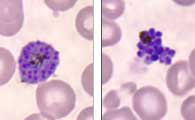
schizont

Four Different Parasites
With four different species of the Plasmodium parasite causing malaria, it becomes important to know if there are differences between the parasites. This is crucial for both diagnosis and treatment.
 Photo courtesy of Boston College. This photomicrograph shows malaria parasites (in orange) in the gut of a mosquito. |
 Photo courtesy of World Health Organization. P. falciparum parasites invade red blood cells, where they multiply. The red blood cell ruptures, sending more parasites into the blood stream. |
Photo courtesy of CDC. The photomicrograph on the left shows a matured P. vivax schizont. On the right, the schizont has ruptured. |
P. falciparum dominates in Africa, where it is endemic—always present in the environment. It causes the most cases of malaria, the most cases of severe malaria, and the most deaths. It is a rapid killer if untreated. P. vivax accounts for about 40% of cases, making it the second most-common form of malaria. It causes much of the malaria in regions other than Africa. Most people do not develop immunity to P. vivax because it comes and goes in epidemic cycles and does not remain in the environment. P. malariae and P. ovale occur more rarely, causing 5% to 10 % of malaria cases. P. vivax, P. ovale, and P. malariae rarely cause death but can cause recurring bouts of the disease. Let’s find out more about why identifying the parasite affects treatment.
This content has been re-published with permission from SEED. Copyright © 2025 Schlumberger Excellence in Education Development (SEED), Inc.

